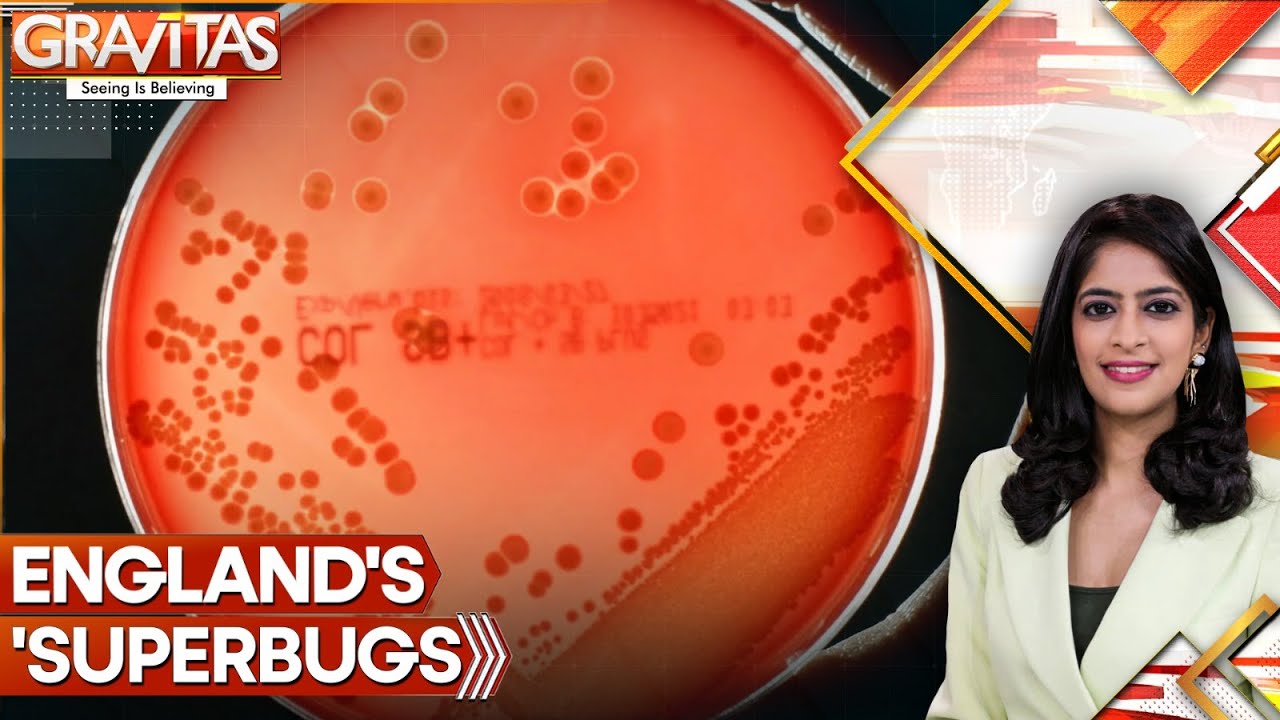

#WION UK Sees Sharp Rise in ‘superbug’ Related Deaths | GRAVITAS
UK Sees Sharp Rise in ‘superbug’ Related Deaths | GRAVITAS
Alarming news from Uk where
New figures from the Uk health security agency have revealed a worrying rise in deaths linked to so-called superbugs
Which are bacteria’s that no longer respond to frontline antibiotics.
Watch this video.
#uk #superbug #wion
About Channel:
WION The World is One News examines global issues with in-depth analysis. We provide much more than the news of the day. Our aim is to empower people to explore their world. With our Global headquarters in New Delhi, we bring you news on the hour, by the hour. We deliver information that is not biased. We are journalists who are neutral to the core and non-partisan when it comes to world politics. People are tired of biased reportage and we stand for a globalized united world. So for us, the World is truly One.
Please keep discussions on this channel clean and respectful and refrain from using racist or sexist slurs and personal insults.
Subscribe to our channel at https://goo.gl/JfY3NI
Check out our website: http://www.wionews.com
Join our WhatsApp Channel: https://bit.ly/455YOQ0
Connect with us on our social media handles:
Facebook: https://ift.tt/HTiSZsl
Twitter: https://twitter.com/WIONews
Instagram: https://ift.tt/yCTS3ur
Follow us on Google News for the latest updates
Zee News:- https://bit.ly/2Ac5G60
Zee Business:- https://bit.ly/36vI2xa
DNA India:- https://bit.ly/2ZDuLRY
WION: https://bit.ly/3gnDb5J
Zee News Apps: https://bit.ly/ZeeNewsApps
Thank you for your support in keeping this website running.💛
View on “Tokyo Trend News”


コメントを送信